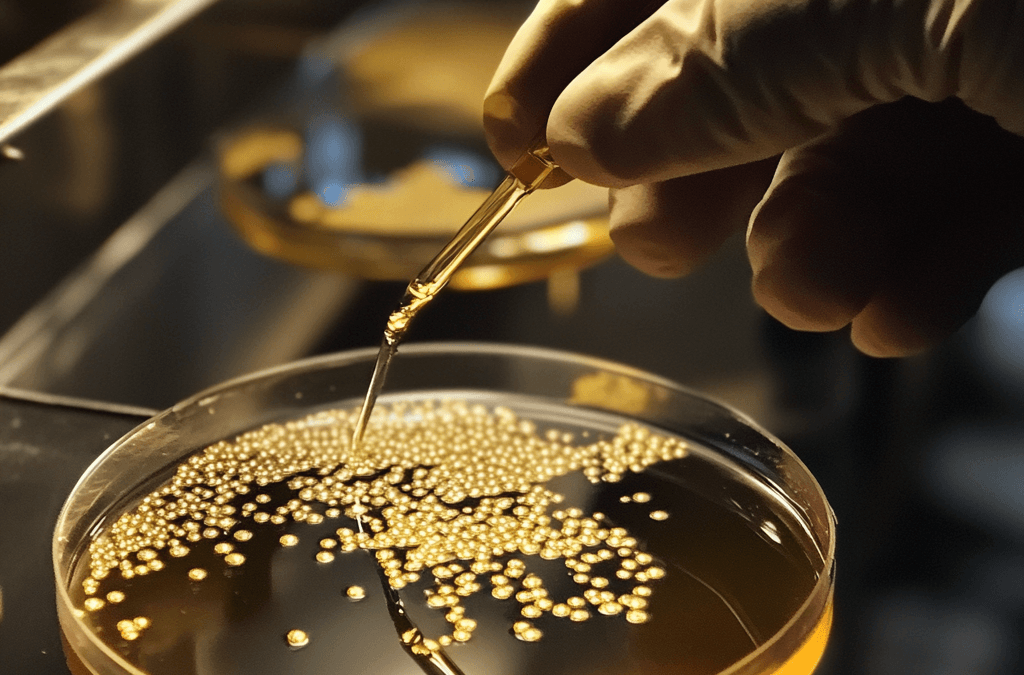
The Importance of Yeast Nutrients in Distilling

by se7en | Mar 15, 2025 | Craft Distilling Trends, News & Updates
Distilling high-proof spirits requires precision, expertise, and an understanding of how alcohol concentration affects both production efficiency and final product quality. Whether crafting vodka, neutral grain spirits, or high-proof whiskeys, mastering the process...

by se7en | Mar 15, 2025 | Craft Distilling Trends, News & Updates
Copper stills in distilling have been a staple of spirit production for centuries. From whiskey and brandy to rum and gin, copper stills play a vital role in refining the final product. Understanding the benefits of copper stills in distilling allows craft distillers...

by se7en | Mar 14, 2025 | Craft Distilling Trends, News & Updates
Carbon filtration in distilling is an essential step for refining spirits, removing unwanted impurities, and enhancing smoothness. This process is widely used in vodka production, light rums, and some whiskeys to create a cleaner, more polished final product....

by se7en | Mar 13, 2025 | Craft Distilling Trends, News & Updates
Yeast nutrients in distilling play a crucial role in ensuring a successful fermentation process, impacting alcohol yield, flavor complexity, and overall spirit quality. Without proper yeast nutrition, fermentation can become sluggish or even stop entirely, leading to...

by se7en | Mar 11, 2025 | Craft Distilling Trends, News & Updates
Distillery safety practices are essential for ensuring a secure work environment while maintaining high-quality spirit production. Operating a distillery involves handling flammable materials, high-proof alcohol, pressurized systems, and heavy machinery, making safety...

by se7en | Mar 10, 2025 | Craft Distilling Trends, News & Updates
Malted barley in whiskey production plays a crucial role in developing the spirit’s flavor, fermentation efficiency, and overall character. Whether used as the primary grain in single malt whiskey or as an enzyme-rich addition to bourbon and rye, malted barley is...